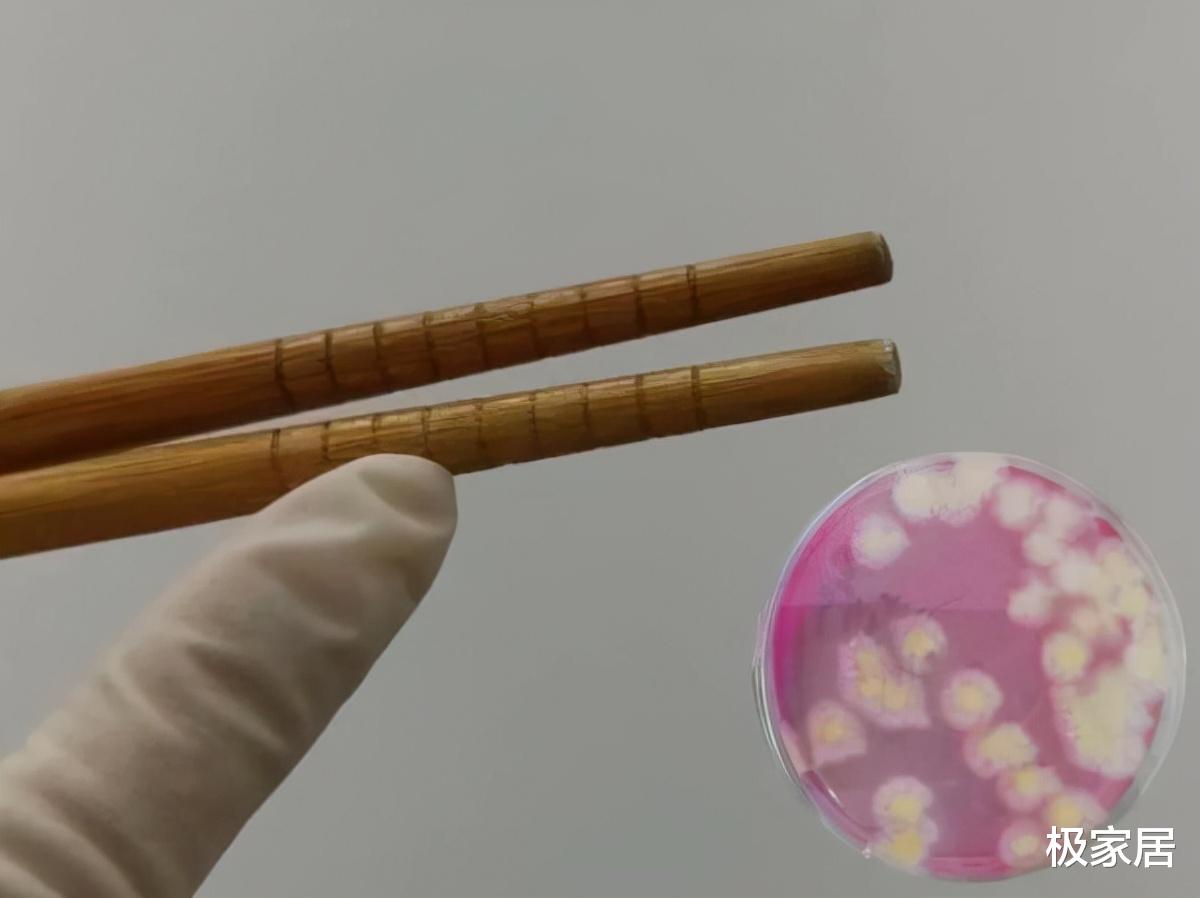
建议大家:再节俭,家中这4样物品也要经常更换,不懂得可以看看

文章图片
文章图片

文章图片

文章图片

文章图片

文章图片

文章图片

文章图片

文章图片

现在人们都希望过上舒适的生活 , 但想要变得更精致 , 我们家里面的物品就要及时更换 。
很多人都很节俭 , 虽然这是一种好习惯 , 但过度的节俭会直接影响到你的生活 。
甚至还会影响到你的身体健康 , 滋生大量的细菌和污垢 , 可别不当回事 。
因此 , 我建议大家:无论你的生活有多节俭 , 家里面这些物品要勤更换 , 不懂的可以看看 。
筷子筷子是我们生活中必备的物品 , 但很多人都喜欢使用传统的木质筷子 。
殊不知 , 这种筷子的缺点是很多的 , 长时间使用 , 筷子会出现发霉和开裂的问题 。
但是 , 很多人都没有在意 , 总认为刷洗干净还可以继续使用 , 要是影响到我们的生活可就不好了 , 一定要及时更换 , 最好是用不锈钢材质的 , 防止细菌滋生 。
若是你喜欢使用木质的筷子 , 但我建议你需要几个月就更换一次 , 不能一双筷子用很长时间 。
油腻腻的抹布清洁厨房卫生的时候 , 都喜欢用脏脏的抹布 , 这种棉质抹布的实用性很差!
用了几次之后 , 上面就变得十分油腻 , 反复清洁都没有效果 , 严重影响到你的家居体验 。
有研究发现:抹布上面会滋生很多的细菌 , 若是继续使用 , 肯定会影响到你的生活 。
我建议大家可以更换成【一次性厨房纸】 , 可以帮助你轻松解决清洁问题 。
这种厨房纸的效果是很好的 , 上面有着珍珠纹的设计 , 可以有效地增加摩擦力 。
去污效果是非常好的 , 直接沾点水就可以擦拭 , 将污垢快速解决 , 用完即可扔掉 , 省事又省力 , 让厨房变得更干净 。
每次清洁的时候 , 直接用一张纸就可以了 , 如果你家有这个问题的话 , 可以尝试一下 。
钢丝球钢丝球是我们经常用到的清洁物品 , 每次出现顽固的污垢 , 都会直接用到它 。
虽然钢丝球的清洁能力很好 , 但是它的槽点很多 , 比如伤手、伤锅 , 搓洗费时费力!
▲钢丝球我家之前就是用钢丝球清洁 , 每次处理起来十分困难 , 锅具上面出现了大量的痕迹 。
因此 , 我们可以试试好用的【不锈钢清洁膏】 , 使用它清洁就变得方便多了 。
- 晒晒我的70㎡小婚房,装修让人太过心动!大家都夸地砖选的好棒
- 奶粉排名前十名中哪款奶粉更值得大家购买呢?
- 开学前准备什么好?
- 确实是不错的做法!10㎡卧室收纳有了还不拥挤,再加个梳妆台也行
- 想给家里老人买血压计,什么牌子的好,请大家推荐?
- 怎么治疗少年白,大家有什么办法?
- 精读小说能训练哪种想象力?是创造想象或者再造想象还是其他的什么?
- 一个年轻怀孕打胎的女孩,再找到男朋友的概率有多大?
- 是什么原因让国内成品油价格一涨再涨?
- 刮痧减肥穴位
特别声明:本站内容均来自网友提供或互联网,仅供参考,请勿用于商业和其他非法用途。如果侵犯了您的权益请与我们联系,我们将在24小时内删除。
